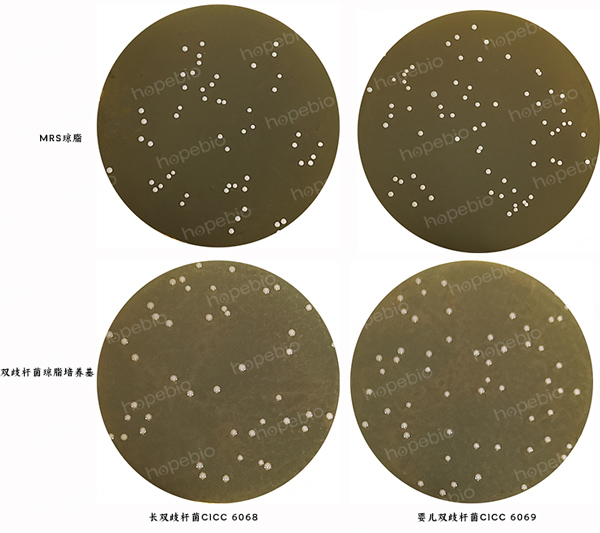

海博微信公众号
海博微信公众号
 海博天猫旗舰店
海博天猫旗舰店


 海博微信公众号
海博微信公众号
 海博天猫旗舰店
海博天猫旗舰店




一、双歧杆菌属情况简要介绍:
双歧杆菌(Bifidobacterium)是1899年由法国学者Tissier从母乳营养儿的粪便中分离出的一种厌氧的革兰氏阳性杆菌。双歧杆菌是有益菌的代表,其中的婴儿双歧杆菌(B.infantis)、青春双歧杆菌(B.adolescentis)、长双歧杆菌(B.longum)和短双歧杆菌(B.breve)等已广泛用于药品或含活菌医疗保健品——微生态调节剂的生产上。
双歧杆菌属于放线菌科,不抗酸、无芽孢,无动力,菌体形态多样,呈短杆状、纤细杆状或球形,可形成各种分支或分叉形态。发酵碳水化合物活跃,发酵产物主要是乙酸和乳酸,二者的摩尔比是3:2,不产生二氧化碳,不产生丁酸和丙酸,触酶阴性。
双歧杆菌的鉴定通常是用双歧杆菌琼脂厌氧培养基进行分离计数,最后进行涂片镜检、生化鉴定及有机酸代谢产物测定。
二、产品用途及原理:
该培养基用于双歧杆菌的分离培养。
蛋白胨和酵母浸粉提供微生物生长所需的碳源、氮源、维生素和生长因子;可溶性淀粉可提供碳源;葡萄糖为可发酵糖类;吐温80、肝浸粉、番茄浸粉和L-半胱氨酸为培养各种双歧杆菌提供生长因子;氯化钠维持均衡的渗透压;琼脂是培养基的凝固剂。
三、培养基配方(g/L):
|
蛋白胨 |
15.0 |
|
葡萄糖 |
20.0 |
|
酵母浸粉 |
2.0 |
|
可溶性淀粉 |
0.5 |
|
氯化钠 |
5.0 |
|
L-半胱氨酸 |
0.5 |
|
番茄浸粉 |
5.0 |
|
肝浸粉 |
0.3 |
|
琼脂 |
20.0 |
|
pH值6.8±0.2(25℃) |
|
四、试验方法:
1. 称取本品70.0g,再吸取1mL吐温80,加热溶解于1000mL蒸馏水中,分装三角瓶,121℃高压灭菌15min-20min,稍冷后倾入无菌平皿,待凝固后备用。
2. 10倍梯度稀释法制备质控菌株菌悬液,吸取适宜梯度的菌悬液涂布接种于待测培养基和参比培养基;
3. 放置于恒温培养箱36℃±1℃厌氧培养48h,观察试验结果。
五、试验结果判断:
接种以下质控菌株,放置36℃±1℃厌氧培养48h,试验结果如图1所示。
|
质控菌株 |
菌株编号 |
接种量(CFU) |
参比或计数培养基 |
方法 |
生长情况 |
其他特征 |
|
长双歧杆菌 |
CICC 6068 |
10-100 |
MRS |
定量 |
PR≥0.7 |
圆形凸起,奶油色,边缘整齐 |
|
婴儿双歧杆菌 |
CICC 6069 |
10-100 |
MRS |
定量 |
PR≥0.7 |
圆形凸起,奶油色,边缘整齐 |
图1 双歧杆菌琼脂培养基微生物质控结果
六、注意事项
婴儿双歧杆菌为厌氧菌,氧气对其有毒害作用,应在厌氧操作箱中操作,若是在正常环境中操作,从厌氧菌暴露在空气中开始到放入厌氧环境中培养结束,整个过程应尽可能快速操作,一般不超过15分钟,暴露时间越长,厌氧菌越容易死亡。
厌氧菌培养相关信息可参考原创文章:专性厌氧菌的培养方法及注意事项-点击查看。
相关产品:
注:本文属海博生物原创,未经允许不得转载。
上一篇:真菌培养基原理和使用方法



